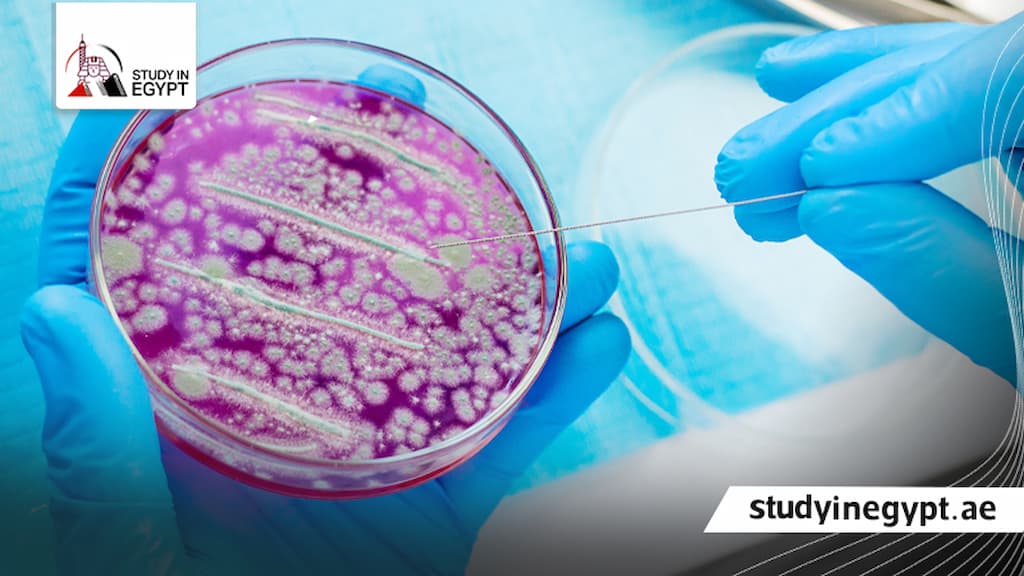

ماجستير ميكروبيولوجي في مصر

تعد دراسة ماجستير ميكروبيولوجي في مصر خيار أكاديمي مميز للطلاب العرب والوافدين الراغبين في التخصص في العلوم الدقيقة، وذلك بسبب قيمة البرنامج العلمية والبحثية، والفرص المهنية التي يوفرها على المستوى المحلي والدولي، ويتيح البرنامج للطلاب دراسة الكائنات الدقيقة على المستويات الجزيئية والوراثية، بجانب التدريب العملي داخل مختبرات متقدمة، مما يطور مهاراتهم البحثية والتطبيقية في مجالات متعددة، مثل الصناعات الغذائية والطبية والدوائية والمختبرات البحثية، ومن خلال متابعة الخطوات الصحيحة في التقديم، يمكن للطلاب تجاوز أي صعوبات والحصول على قبول سريع في أفضل الجامعات المصرية، مما يضمن الانضمام لمسار علمي ومهني مرموق.
لماذا يعد تخصص الميكروبيولوجي من أهم التخصصات العلمية؟
تعد دراسة ماجستير ميكروبيولوجي في مصر من البرامج ذات القيمة العلمية والمهنية المرتفعة، وخاصة في ظل التحديات الصحية والبيئية المتسارعة التي يشهدها العالم، وتبرز أهمية هذا التخصص في عدة جوانب أساسية، من أهمها التالي:
- يساعد البرنامج في إعداد كوادر بحثية مؤهلة للتعامل مع القضايا المرتبطة بالأمراض المعدية وسلامة الغذاء وحماية البيئة، مما يدعم جهود الوقاية والسيطرة.
- تكمُن أهمية دراسة ماجستير ميكروبيولوجي في مصر في تعميق الفهم العلمي للكائنات الدقيقة التي تؤدي دور هام في حياة الإنسان والبيئة، سواء في تحقيق التوازن البيئي أو في الصناعات الغذائية والدوائية.
- يتيح البرنامج للطلاب دراسة الميكروبات على المستويات الجزيئية والوراثية بصورة متقدمة، وهي جوانب لا يتم التوسع فيها خلال مرحلة البكالوريوس.
- يوفر بيئة بحثية متخصصة تساعد الطلاب في دراسة قضايا صحية معاصرة مثل مقاومة المضادات الحيوية وتلوث المياه والغذاء، والأمراض المختلفة، مما يساعد في إنتاج معرفة علمية تطبيقية تخدم المجتمع.
- تتجلى أهمية ماجستير ميكروبيولوجي في دعم منظومة الأمن الصحي، من خلال تأهيل متخصصين قادرين على التشخيص المبكر وفهم آليات العدوى، ووضع استراتيجيات فعالة للوقاية والمكافحة.
- تفتح دراسة ماجستير ميكروبيولوجي في مصر آفاق وظيفية متعددة أمام الخريجين، سواء في المعامل الطبية أو معامل التحاليل أو جهات الرقابة الصحية، وغيرها من المجالات ذات الصلة.
- يسهم في إنتاج أدوية جديدة ومكافحة مقاومة البكتيريا للأدوية.
- يضمن مراقبة الأغذية والمياه وحماية المستهلك من التلوث الميكروبي.
هل شهادة ماجستير ميكروبيولوجي في مصر معترف بها دوليًا؟
نعم، تعد شهادة ماجستير ميكروبيولوجي في مصر معترف بها رسميًا داخل مصر، حيث يتم تقديم البرنامج في عدد من الجامعات الحكومية والخاصة المعتمدة من المجلس الأعلى للجامعات، ويضمن ذلك حصول الطلاب الوافدين على مؤهل أكاديمي معتمد يمكن الاعتماد عليه في استكمال الدراسات العليا أو الالتحاق بسوق العمل.
أما على المستوى الدولي، فإن درجة الماجستير تكون قابلة للاعتراف خارج مصر بشرط أن تكون صادرة من جامعة معترف بها رسميًا، وأن تستوفي متطلبات الجهة أو الدولة المراد معادلة الشهادة بها، وتخضع برامج الميكروبيولوجي في الجامعات المعتمدة لمعايير أكاديمية وبحثية تتماشى مع الأسس العلمية العالمية، مما يعزز فرص قبولها في المؤسسات الأكاديمية والبحثية بالخارج.
أفضل الجامعات لدراسة ماجستير ميكروبيولوجي في مصر
يهتم الكثير من الطلاب بالتعرف على الجامعات التي تتيح دراسة ماجستير ميكروبيولوجي في مصر، وهي تتمثل في التالي:
جامعة القاهرة
تعد جامعة القاهرة من أبرز الجامعات المصرية في المجال الطبي والبحثي، حيث تقدم برنامج ماجستير ميكروبيولوجي محتوى علمي متطور يجمع بين الدراسة النظرية والتطبيق العملي داخل معامل مجهزة، وتتيح فرص بحثية مميزة للطلاب في جميع التخصصات الدقيقة.
جامعة المنصورة
تتميز جامعة المنصورة بسمعة أكاديمية قوية في العلوم الطبية، وتوفر برنامج ماجستير ميكروبيولوجي يركز على الجوانب البحثية والتطبيقات المعملية الحديثة، مما يساعد الطلاب على تنمية مهاراتهم العلمية وإعدادهم للعمل في المجالات الأكاديمية والمخبرية المتخصصة.
جامعة عين شمس
تقدم جامعة عين شمس برنامج ماجستير ميكروبيولوجي وفقًا لمعايير أكاديمية دقيقة، بجانب اهتمام واضح بالتدريب العملي والبحث العلمي، كما تتيح للطلاب فرصة المشاركة في مشروعات بحثية متقدمة تدعم خبراتهم وتؤهلهم لاستكمال الدراسات العليا أو العمل المتخصص.
جامعة الإسكندرية
توفر جامعة الإسكندرية دراسة ماجستير ميكروبيولوجي من خلال مناهج حديثة ومعامل متطورة، وتهتم بتعزيز الجانب التطبيقي والبحثي لدى الطلاب، مما يساعد في إعداد كوادر علمية تكون قادرة على مواكبة التطورات في مجالات الميكروبيولوجي المختلفة.
أفضل كليات الصيدلة لدراسة ماجستير الميكروبيولوجي في مصر
توفر الجامعات المصرية برامج ماجستير ميكروبيولوجي في مصر من خلال كليات الصيدلة المعتمدة، حيث تجمع الدراسة بين الأساس النظري المتعمق والتدريب العملي داخل معامل بحثية متطورة، مما يتيح للطلاب اكتساب خبرات أكاديمية ومخبرية تؤهلهم للعمل والبحث العلمي المتخصص، وجاءت أفضل الكليات كالتالي:
كلية الصيدلة جامعة القاهرة
تعد من أعرق كليات الصيدلة في مصر، وتقدم برنامج ماجستير ميكروبيولوجي يعتمد على مناهج حديثة وتدريب عملي مكثف داخل معامل مجهزة، بجانب الاهتمام بالبحث العلمي وإعداد رسائل علمية تساعد في خدمة المجالات الدوائية والطبية.
كلية الصيدلة جامعة عين شمس
تتميز بتقديم برنامج أكاديمي متكامل في الميكروبيولوجي الصيدلي يجمع بين الدراسة النظرية والتطبيقات المعملية الدقيقة، بجانب توفير بيئة بحثية داعمة تشجع الطلاب على الابتكار والمشاركة في مشروعات علمية متخصصة ومتقدمة.
كلية الصيدلة جامعة الإسكندرية
توفر برنامج ماجستير يركز على الجوانب التطبيقية والتحليلية في علم الميكروبات، وتدريب عملي داخل معامل حديثة، مما يساعد الطلاب على تنمية مهاراتهم البحثية وتأهيلهم للعمل في القطاعات الدوائية والمختبرات المتخصصة.
كلية الصيدلة جامعة المنصورة
تقدم برنامج مميز في ماجستير الميكروبيولوجي يعتمد على أسس علمية دقيقة وتدريب معملي متقدم، واهتمام خاص بمجالات الميكروبيولوجي الدوائي والتقنيات الحديثة، مما يعزز فرص الخريجين في المسار الأكاديمي والمهني.
كلية الصيدلة جامعة أسيوط
تطرح برنامج ماجستير ميكروبيولوجي يركز على إعداد كوادر بحثية مؤهلة، من خلال مناهج متطورة وتدريب عملي شامل داخل معامل الكلية، ودعم مستمر للأنشطة البحثية والتطبيقات المرتبطة بالصناعة الدوائية والمجالات الصحية.
يمكن الاستعانة بمكتب ادرس في مصر لمساعدة الطلاب الوافدين في اختيار الكليات المناسبة لهم لدراسة ماجستير ميكروبيولوجي في مصر، فقط تواصل معنا عبر الواتس اب.
شروط القبول في ماجستير ميكروبيولوجي في مصر للطلاب الوافدين
يحرص الكثير من الطلاب على التعرف على المتطلبات وشروط ماجستير ميكروبيولوجي في مصر، وجاءت هذه الشروط كالتالي:
- يكون الطالب حاصل على شهادة البكالوريوس من أحد الجامعات المعتمدة في مصر.
- الحصول على معدل تراكمي يتراوح من مقبول حتى جيد.
- الالتزام بمعادلة الشهادات من المجلس الأعلى للجامعات في مصر.
- يلتزم الطالب توثيق كافة الأوراق والمستندات من السفارة المصرية ووزارة الخارجية في دولته.
- يقدم الطالب شهادة الامتياز.
- يتم سداد الرسوم الدراسية في المواعيد المحددة.
للمزيد تعرف على: شروط التقديم للماجستير في مصر بالتفصيل
الأوراق المطلوبة للتقديم في ماجستير الميكروبيولوجي
عند التسجيل في برنامج ماجستير ميكروبيولوجي في مصر، يلتزم الطالب بتجهيز مجموعة من المستندات تتمثل في التالي:
- تقديم شهادة البكالوريوس وبيان التقديرات.
- يقدم صورة من جواز السفر الخاص بالطالب.
- صورة من بطاقة الهوية الوطنية أو كارت العائلة.
- نسخة من شهادة الميلاد الرسمية.
- عدد 6 صور شخصية تكون الخلفية بيضاء والصور حديثة.
- صورة من شهادة الامتياز.
معدل القبول المطلوب للتسجيل بماجستير ميكروبيولوجي في مصر
يختلف معدل القبول في ماجستير ميكروبيولوجي في مصر للطلاب العرب حسب الجامعة المتقدم إليها، وبوجه عام يبلغ الحد الأدنى للقبول جامعات مثل جامعة القاهرة وجامعة عين شمس وجامعة الإسكندرية وجامعة المنصورة وجامعة أسيوط نحو جيد كحد أدنى، أما في باقي الجامعات المصرية، فقد يصل الحد الأدنى للقبول إلى مقبول وفقًا للضوابط الخاصة بكل مؤسسة.
يساعد مكتب ادرس في مصر الطلاب في الاطلاع على معدلات القبول اللازمة عند الدراسة في ماجستير ميكروبيولوجي في مصر، ويمكنك التواصل معنا عبر الواتس اب للتعرف على كافة التفاصيل.
مسارات وتخصصات ماجستير الميكروبيولوجي في مصر
يوفر ماجستير الميكروبيولوجي في مصر مسارات متعددة، مع مناهج حديثة وتقنيات مختبرية متطورة لتطوير مهارات البحث العلمي، التحليل الدقيق، والتطبيق العملي في المجالات الطبية، الغذائية والبيئية، ومن أبرز التخصصات والمسارات المرتبطة بالبرنامج كالتالي:
- ميكروبيولوجيا الأغذية
- بكتريولوجيا طبية
- ميكروبيولوجيا صناعية متقدمة
- ميكروبيولوجيا تطبيقية بيئية
- الميكروبيولوجيا الصيدلانية
- الميكروبيولوجيا الصناعية الدوائية
تكلفة دراسة ماجستير ميكروبيولوجي في مصر للطلاب الوافدين والسعوديين
يبحث الكثير من الطلاب عن رسوم الدراسة في ماجستير ميكروبيولوجي في مصر، وهي تتمثل في التالي:
الرسوم الدراسية السنوية
تختلف رسوم الدراسة في ماجستير ميكروبيولوجي في مصر، حسب الجامعة التي يلتحق بها الطالب، أيضا باختلاف الكلية، حيث تتراوح رسوم الدرجة العلمية من كلية العلوم بين 5000 إلى 6000 دولار أمريكي سنويا، بينما الحصول على الدرجة من كلية الصيدلة تتراوح التكلفة بين 5500 إلى 6500 دولار سنويا.
الرسوم الإدارية
- رسوم القيد الجامعي تبلغ 1500 دولار أمريكي.
- رسوم معادلة شهادة البكالوريوس تبلغ 300 دولار أمريكي.
- رسوم فتح ملف التقديم تبلغ 170 دولار أمريكي.
- رسوم خدمة التنسيق تبلغ 170 دولار أمريكي.
- رسوم الاشتراك في نادي الوافدين تبلغ 150 دولار أمريكي.
مدة دراسة ماجستير ميكروبيولوجي في مصر ونظام الدراسة
تتحدد مدة دراسة ماجستير ميكروبيولوجي في مصر وفقًا للوائح كل جامعة، ومدى التزام الطالب بمتطلبات البرنامج الأكاديمية والبحثية، حيث أن مدة الدراسة بشكل عام لا تقل مدة الدراسة عن سنتين كحد أدنى، وقد تمتد حتى خمس سنوات كحد أقصى لاستكمال جميع المتطلبات.
ويتضمن نظام الدراسة مرحلتين أساسيتين، الأولى دراسة مقررات نظرية وعملية تهدف إلى تعميق المعرفة العلمية وتنمية المهارات المعملية، والثانية إعداد رسالة علمية تعتمد على إجراء بحث تطبيقي أو تجريبي تحت إشراف أعضاء هيئة تدريس متخصصين، ويتم مناقشة الرسالة أمام لجنة علمية معتمدة للحصول على الدرجة.
نظام الساعات المعتمدة وتوزيع الساعات على الخطة الدراسية
يعتمد ماجستير ميكروبيولوجي في مصر على نظام الساعات المعتمدة، حيث يبلغ إجمالي الساعات المطلوبة في المادة نحو 48 ساعة معتمدة، وتنقسم هذه الساعات إلى 24 ساعة معتمدة مخصصة للمقررات الدراسية، تشمل مواد إجبارية وأخرى اختيارية، بالإضافة إلى 24 ساعة معتمدة مخصصة لإعداد رسالة الماجستير، ويشترط النظام اجتياز جميع المقررات بنجاح والحصول على التقديرات المحددة وفقًا للائحة الداخلية للكلية.
المقررات الدراسية في ماجستير الميكروبيولوجي
يدرس ماجستير ميكروبيولوجي في مصر من خلال مجموعة من المقررات الأساسية والتخصصية التي تمزج بين الجانب النظري والتطبيق العملي داخل المعامل، مما يساعد الطلاب على تنمية مهاراتهم البحثية والتحليلية وتأهيلهم لسوق العمل المحلي والدولي، وجاءت المقررات كالتالي:
مقررات ماجستير الميكروبيولوجي (كلية الصيدلة)
- میكروبیولوجیا متقدمة.
- أساسیات المناعة.
- التعقيم والرقابة الميكروبيولوجية وتأكيد الجودة.
- المضادات المیكروبیة والمقاومة المیكروبیة.
- میكروبیولوجیا متقدمة.
- المستحضرات المناعية و طرق المناعة و تطبيفاتها.
- تقنیات متطورة لأبحاث المیكروبیولوجى.
- استراتيجيات المضادات الحيوية والمضادات الفیروسیة الحدیثة.
- التكنولوجیا الحیویة.
مقررات ماجستير الميكروبيولوجي (كلية العلوم)
- فطريــات
- فيروســات واكتينوميسيتات.
- بكتريــــا.
- أيض وتحولات ميكروبية.
- أمراض نبات.
- فسيولوجى ايض + منظمات.
- علم البكتيريا المتقدم والسموم الميكروبية.
- زراعة الطحالب ووظائفها.
- علم الفيروسات المتقدم وعلم المناعة.
هل يمكن دراسة ماجستير ميكروبيولوجي في مصر عن بعد؟
لا تتيح الجامعات المصرية برامج ماجستير ميكروبيولوجي بنظام الدراسة عن بعد، وذلك بسبب اعتماد التخصص على الحضور الفعلي للمحاضرات والتدريب العملي داخل المعامل، فالحضور عنصر أساسي لاكتساب المهارات البحثية والتطبيقية المطلوبة للحصول على الدرجة العلمية المعتمدة.
وتلزم طبيعة البرنامج إجراء تجارب معملية وأبحاث تطبيقية وإعداد رسالة علمية تحت إشراف أكاديمي مباشر، مما يجعل الانتظام الحضوري ضرورة أكاديمية، وعلى الرغم من ذلك قد توفر بعض الجامعات المرونة في حضور بعض المحاضرات النظرية عن بعد، والالتزام بالحضور الفعلي في التدريبات العملية والاختبارات النهائية وفقًا للوائح المعتمدة.
الفرق بين الميكروبيولوجي والبيولوجيا الجزيئية
في ضوء التعرف على ماجستير ميكروبيولوجي في مصر، يهتم الطلاب بالاطلاع على الفرق بين الميكروبيولوجي والبيولوجيا الجزيئية، وهو كالتالي:
| البند | الميكروبيولوجي | البيولوجيا الجزيئية |
| التركيز الأساسي | دراسة الكائنات الدقيقة مثل البكتيريا والفيروسات والفطريات والطفيليات وسلوكها وأمراضها، ودورها في البيئة والصحة. | دراسة العمليات الجزيئية داخل الخلايا، مثل التعبير الجيني والنسخ والترجمة، وتفاعلات البروتينات والأحماض النووية. |
| الأدوات والتقنيات | التحليل المخبري للكائنات الدقيقة وزراعة الميكروبات واختبارات مقاومة المضادات الحيوية وتقنيات التعقيم والمجهر الضوئي والالكتروني. | تقنيات تحليل الجينات والتسلسل الجيني وتقنيات البروتين وطرق تعديل الجينات. |
| التطبيقات العملية | مكافحة العدوى وتطوير اللقاحات ومراقبة الجودة الغذائية والدوائية والبحث البيئي والصناعي. | أبحاث السرطان والهندسة الوراثية والعلاج الجيني ودراسة الجينات والبروتينات في الخلايا. |
مستقبل خريجي ماجستير الميكروبيولوجي بدول الخليج
توفر شهادة ماجستير ميكروبيولوجي في مصر للطلاب الوافدين فرص مهنية مميزة في دول الخليج، بسبب اعتماد الجامعات المصرية وبرامجها، مما يعزز قدرة الخريجين على المنافسة في مجالات العلوم الطبية والصناعية والبحثية، وجاءت فرص العمل كالتالي:
- العمل في مراكز مكافحة العدوى والمختبرات البحثية بالمستشفيات، والمراكز الطبية المتخصصة، لدعم الجوانب الوقائية والبحثية في الصحة العامة.
- الانضمام إلى معامل التحاليل الطبية والمستشفيات، مما يشمل بنوك الدم وأقسام الطب الشرعي لتطبيق الخبرات المخبرية والتحليلية المتقدمة.
- العمل ضمن المختبرات البحثية التابعة للوزارات والهيئات الحكومية، مثل وزارة البيئة المصرية وهيئة المصل واللقاح، للإشراف على المشاريع البحثية والمختبرية.
- يساعد في مراقبة الجودة، لضمان سلامة المنتجات الغذائية والمستحضرات الصحية، وتطبيق المعايير العلمية والمخبرية الدولية.
- الالتحاق بأقسام البحث والتطوير في الصناعات الدوائية، والمشاركة في إنتاج الأدوية، مثل المضادات الحيوية واللقاحات والأمصال والإشراف على مراقبة الجودة.
مواعيد التقديم والتسجيل في برنامج ماجستير ميكروبيولوجي في مصر
يهتم الطلاب بالتعرف على المواعيد الرسمية الخاصة بالتقديم في ماجستير ميكروبيولوجي في مصر، وجاءت المواعيد كالتالي:
- المرحلة الأولى تبدأ من 1 مايو حتى 31 يوليو.
- المرحلة الثانية تبدأ من 1 أغسطس حتى 30 سبتمبر.
- المرحلة الثالثة تبدأ من 1 أكتوبر حتى 15 نوفمبر.
- المرحلة الرابعة تبدأ من 1 ديسمبر حتى 15 فبراير.
أخطاء تؤدي إلى تأخير أو رفض القبول بالبرنامج
يوجد عدد من الأخطاء الشائعة التي قد تؤدي إلى تأخير أو رفض قبول الطلاب في برامج ماجستير ميكروبيولوجي في مصر، ويجب على الطلاب الوافدين الانتباه لها لتجنب أي مشاكل أثناء التقديم، وجاءت الأخطاء كالتالي:
- تقديم شهادات أو معدلات أقل من الحد الأدنى لكل كلية أو جامعة يؤدي إلى رفض الطلب تلقائيًا.
- عدم تقديم النسخ الرسمية للشهادات أو تخطي خطوات التوثيق اللازمة من الجهات المختصة يعيق عملية القبول.
- أخطاء في تعبئة استمارات التقديم، مثل كتابة بيانات خاطئة أو غير مكتملة التي قد تؤدي إلى تأخير مراجعة الطلب أو رفضه نهائي.
- التأخر في إرسال الطلبات أو دفع الرسوم المقررة قبل الموعد النهائي قد يؤدي إلى رفض القبول.
- التقديم على مسارات أو تخصصات لا تتوافق مع مؤهلات الطالب الأكاديمية يؤدي إلى رفض الطلب.
- بعض الجامعات تشترط اجتياز مقابلات أو اختبارات تقييمية، وفشل الطالب فيها قد يمنع القبول.
- عدم متابعة حالة الطلب أو تقديم المستندات المطلوبة عند الطلب من الجامعة قد يؤدي إلى الرفض.
لتفادي كل تلك الأخطاء ولضمان قبول سلس في الجامعات المصرية، يكون بإمكانك التواصل مع مكتب ادرس في مصر عبر الواتساب.
خطوات التقديم عبر مكتب ادرس فى مصر للطلاب العرب
يمكنك التسجيل في برنامج ماجستير ميكروبيولوجي في مصر بسهولة من خلال مكتب ادرس في مصر باعتباره أحد المكاتب المتخصصة في مجال الخدمات والقبولات الجامعية، كل ما عليك اتباع الخطوات التالية:
الخطوة الأولى يقدم الطالب صور المستندات
- نسخة من شهادة البكالوريوس وبيان التقديرات.
- صورة جواز السفر الخاص بالطالب.
- نسخة من شهادة الميلاد الرسمية.
الخطوة الثانية يقدم الطالب أصول المستندات
- أصل الوكالة.
- شهادة البكالوريوس الأصلية وبيان الدرجات.
- عدد 6 صور شخصية للطالب حديثة والخلفية بيضاء.
الخطوة الثالثة القيام بإرسال هذه المستندات عن طريق أحد شركات الشحن التالية:
- DHL.
- Aramex.
- FedEx.
- smsa.
- البريد السريع.
تعرف أيضًا على لائحة: ماجستير مكافحة العدوى معهد البحوث الطبية
لماذا يثق بنا الطلاب من دول الخليج؟
يعتبر مكتب ادرس في مصر من المكاتب الرائدة في تقديم الخدمات التعليمية والاستشارية للطلاب من دول الخليج، بسبب خبراته الطويلة وفريق العمل المتخصص الذي يضمن تجربة دراسية آمنة، ويقدم المكتب مجموعة متكاملة من الخدمات التي تجعل رحلة الدراسة أكثر تنظيم وجاءت مميزات المكتب كالتالي:
- يرشح خبراء المكتب للطلاب الجامعات والكليات التي تقدم تعليم عالي الجودة، وتزويدهم بجميع المعلومات حول متطلبات القبول والشروط الأكاديمية.
- يجيب المكتب على جميع تساؤلات واستفسارات الطلاب بشكل مستمر لضمان وضوح الرؤية واتخاذ القرار المناسب.
- يساعد المكتب الطلاب على إعداد كافة المستندات اللازمة للتقديم وتوثيقها رسميًا، مما يوفر الوقت والجهد.
- يتولى المكتب متابعة كافة الخطوات الرسمية لضمان حصول الطلاب على القبول الجامعي في المؤسسة التعليمية المرغوبة.
- يوفر المكتب متابعة ودعم شامل لمواجهة أي تحديات قد تواجه الطلاب أثناء فترة دراستهم في مصر.
- يساعد الطلاب على تأمين السكن المناسب والإقامة، وكذلك استخراج التأشيرات الدراسية لضمان تجربة دراسية مريحة وآمنة.
في الختام، تفتح دراسة ماجستير ميكروبيولوجي في مصر آفاق علمية ومهنية متعددة، سواء في البحث الأكاديمي أو في القطاعات الصحية والصناعية، كما أن اتباع شروط القبول بدقة، وتجهيز المستندات المطلوبة ومتابعة إجراءات التسجيل، بالإضافة إلى اختيار الجامعة والكليات المناسبة، فهو يعد عامل رئيسي لضمان نجاح تجربة الدراسة، ويمكنك التواصل مع مكتب ادرس في مصر عبر الواتس اب لمساعدتك في إنهاء كافة الإجراءات الخاصة بالتقديم.
الأسئلة الشائعة حول ماجستير ميكروبيولوجي في مصر
كم مدة دراسة ماجستير الميكروبيولوجي؟
تبلغ مدة دراسة ماجستير ميكروبيولوجي في مصر من سنتين حتى خمس سنوات دراسية تتضمن مقررات دراسية وفترات تدريب عملي وإعداد رسالة بحثية.
كم تكلفة دراسة ماجستير ميكروبيولوجي في مصر؟
تتراوح تكاليف دراسة ماجستير ميكروبيولوجي في مصر من 5000 إلى 6000 دولار بالنسبة لكليات العلوم، بينما تتراوح التكلفة بين 5500 حتى 6500 دولار أمريكي سنويا لكليات الصيدلة.






